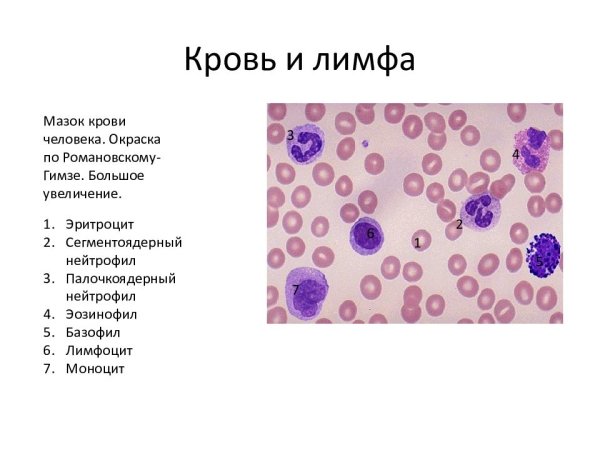
Окраска мазка крови по Романовскому Гимза
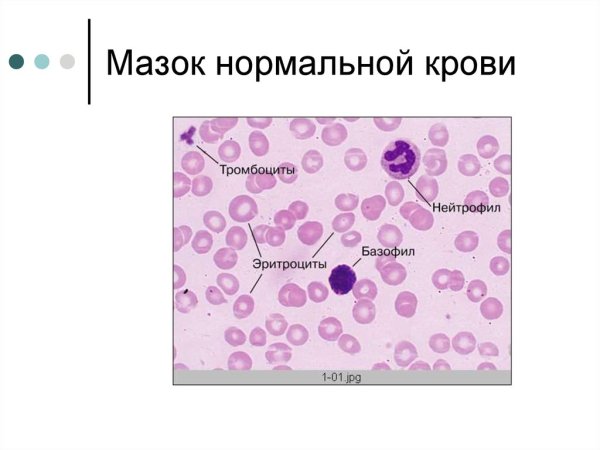
Мазок крови человека гистологический препарат
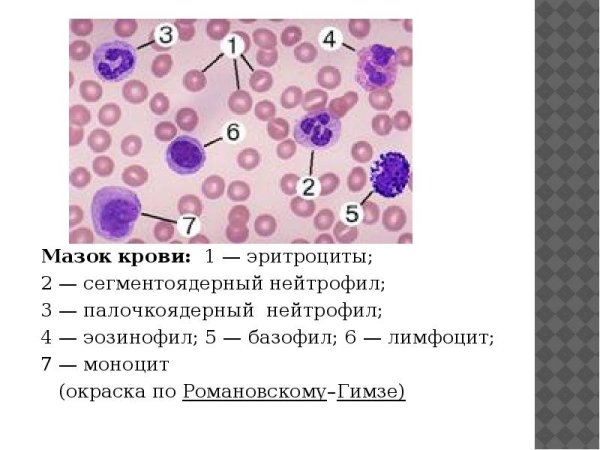
Мазок крови человека гистология препарат по Романовскому
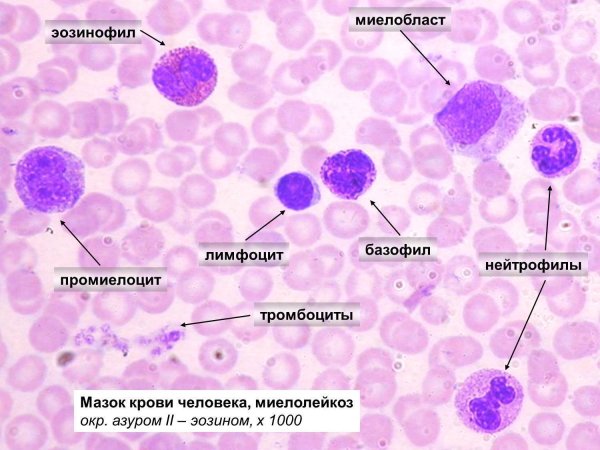
Мазок крови гистология препарат
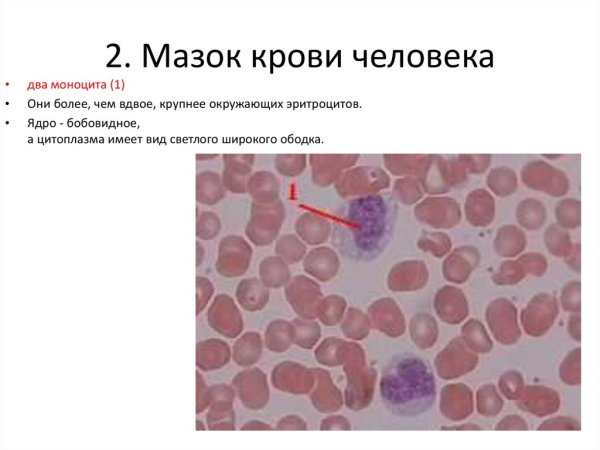
Мазок крови больного малярией
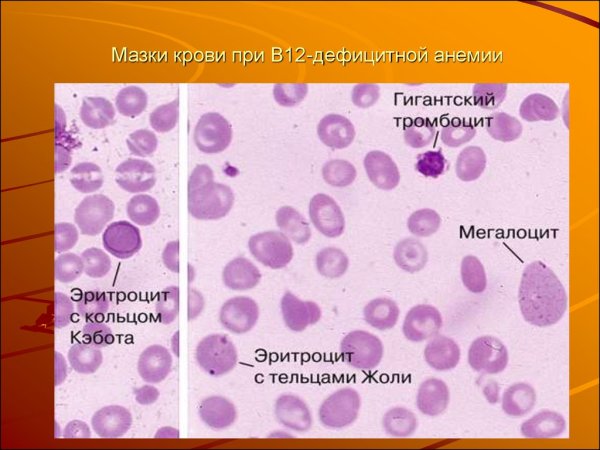
Мегалобластная анемия мазок крови
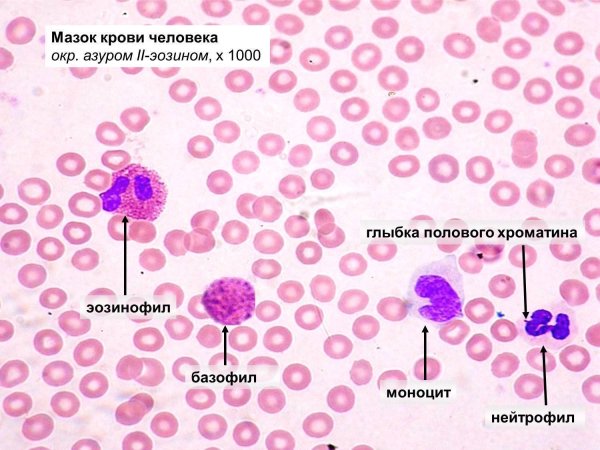
Мазок крови человека гистология препарат
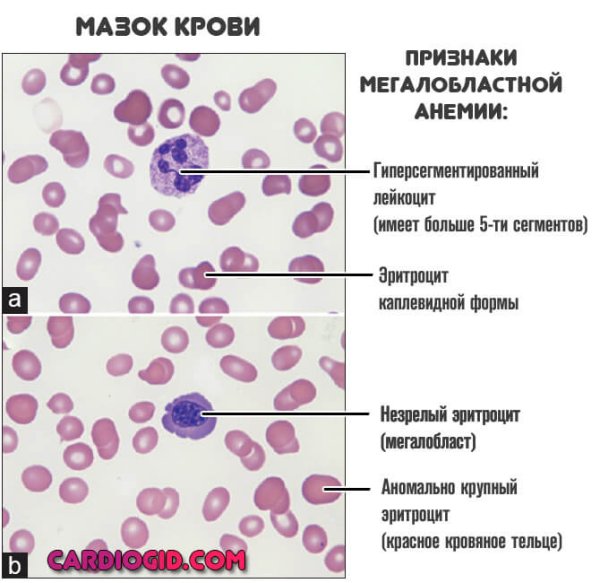
Мегалобластная анемия мазок крови

Мазок крови рисунок - это уникальный способ изображения капли крови, который может быть использован в различных областях. Благодаря своей оригинальности и неповторимости, этот рисунок привлекает внимание и вызывает интерес окружающих. Он может быть использован в медицинских и научных исследованиях, дизайне и искусстве. Точное и реалистичное изображение капли крови помогает передать ее структуру и особенности, что может быть полезно для анализа и диагностики различных заболеваний. Кроме того, такой рисунок может служить источником вдохновения для художников и дизайнеров, которые ищут новые идеи и необычные решения. Мазок крови рисунок - это не только эстетически привлекательная композиция, но и возможность раскрыть новые грани и потенциал этого неповторимого материала.
Мазок крови человека рисунок с обозначениями
Форменные элементы крови гистология препарат
Мазок крови человека гистология
Зарисовка форменных элементов крови мазок крови человека
Мазок крови человека гистология препарат
Клетки крови мазок гистология
Мазок крови человека форменные элементы
Атлас Юшканцева гистология
Лейкоциты мазок крови человека гистология
Лейкоцитарная формула микроскопия
Мазок крови гистология препарат
Мазок крови гистология препарат
Клетки форменных элементов периферической крови в норме
Форменные элементы крови гистология
Мазок крови человека гематоксилин эозин
Лейкоциты гистология строение
Лейкоциты гистология строение
Форменные элементы крови эритроциты ,лимфоциты ,тромбоциты
Мазок крови гистология препарат
Мазок крови человека рисунок
Окраска мазка крови по Романовскому Гимза
Клетки крови мазок гистология
Мазок крови человека гистологический препарат
Мазок крови человека окраска гематоксилин эозин
Мазок крови человека лейкоциты препарат
Клетки крови человека мазок
Форменные элементы крови гистология препарат
Форменные элементы крови гистология
Мазок крови крупного рогатого скота
Мазок крови человека гистология препарат по Романовскому
Мазок крови гистология препарат
Препарат мазок крови человека окраска Азур 2-эозином
Препарат мазок крови человека окраска Азур 2-эозином
Кровь мазок крови человека гистология
Мазок крови больного малярией
Клетки крови мазок гистология
Мазок крови окрашенный по Романовскому-Гимзе
Мегалобластная анемия мазок крови
Мазок крови человека гистология препарат
Форменные элементы крови мазок крови лягушки
Лейкоциты базофилы эозинофилы
Мазок крови окраска Азур 2 эозином по Романовскому
Препарат мазок крови человека . Окраска по Романовскому-Гимза
Лейкоциты крови человека под микроскопом
Мегалобластная анемия мазок крови
Лимфоцитарная формула микроскопия

Grizly.club
Grizly.club